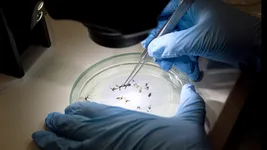
brote de dengue: ¿que dicen los infectologos sobre la vacunacion? brote de dengue: ¿que dicen los infectologos sobre la vacunacion?

Los contagios de dengue en La Plata aumentaron un 228% entre el 24 de febrero y pasado 2 de enero, según revelan los últimos dos boletines epidemiológicos publicados por el Ministerio de Salud de la provincia de Buenos Aires.
El Ministerio de Salud bonaerense publicó un nuevo informe con cifras del dengue en La Plata que generan preocupación.
Los contagios de dengue en La Plata aumentaron un 228% entre el 24 de febrero y pasado 2 de enero, según revelan los últimos dos boletines epidemiológicos publicados por el Ministerio de Salud de la provincia de Buenos Aires.
Las estadísticas son preocupantes, fundamentalmente porque, pese al rápido y sostenido aumento de los contagios, todos los expertos indican que aún no se llegó al pico y pronostican que este tendría lugar entre la segunda semana de este mes y la primera de abril.
Los especialistas de la Comisión Nacional de Inmunizaciones manifestaron su postura sobre las dos vacunas aprobadas contra el dengue en Argentina.
El informe publicado corresponde a la novena semana epidemiológica y recoge datos entre el 25 de febrero pasado y el 2 de marzo. En ese periodo los contagios en la ciudad se triplicaron, pasando de 75 a 246. En el mismo lapso, en la provincia ocurrió algo similar: de 7.883 casos confirmados se pasó a 13.924, 12.662 de los cuales son autóctonos y 1.262 importados.
La Plata se encuentra, desde hace semanas, "en brote" de dengue. Las autoridades provinciales encendieron las alarmas al comprobar el rápido aumento de los casos detectados en la ciudad. En total, 31 municipios se encuentran en esa misma situación y los distritos con mayor incidencia de contagios son Lanús, San Isidro, Lomas de Zamora, General San Martín, Tres de Febrero, Avellaneda, José C. Paz, Quilmes, Hurlingham, Morón y San Miguel.
El aumento de los casos confirmados de dengue mantiene alerta a los expertos, que ya calificaron esta situación como el mayor brote de la historia de la provincia.
Según datos del Ministerio de Salud de la Nación, en las primeras 8 semanas del año se registraron en total 57.461 casos de dengue en el país, con reportes en 18 provincias; un 77% de los 74.555 casos registrados en la temporada delimitada desde fines de octubre pasado. Las alarmantes estadísticas indican un aumento del 2.153% con respecto al mismo período de 2023, cuando se registraron 2.550 casos.
En ese mismo periodo en La Plata solo fue confirmada una muerte a causa de la enfermedad, en la provincia 16 personas perdieron la vida y a nivel nacional el conteo de víctimas asciende a 47, 37 de las cuales fallecieron en lo que va del 2024.